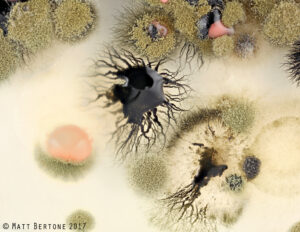
Various molds and yeasts growing on culture media

PDIC Discontinuing Household Mold Identification Service
Beginning January 17th, 2023, the NC State Plant Disease and Insect Clinic (PDIC) will no longer be providing identification …
Extension and research at NC State address timely issues impacting our state. Extension delivers trusted information directly into the hands of farmers and agribusinesses, helping them translate knowledge into solutions that grow our economy and communities.
El inglés es el idioma de control de esta página. En la medida en que haya algún conflicto entre la traducción al inglés y la traducción, el inglés prevalece.
Al hacer clic en el enlace de traducción se activa un servicio de traducción gratuito para convertir la página al español. Al igual que con cualquier traducción por Internet, la conversión no es sensible al contexto y puede que no traduzca el texto en su significado original. NC State Extension no garantiza la exactitud del texto traducido. Por favor, tenga en cuenta que algunas aplicaciones y/o servicios pueden no funcionar como se espera cuando se traducen.
Inglês é o idioma de controle desta página. Na medida que haja algum conflito entre o texto original em Inglês e a tradução, o Inglês prevalece.
Ao clicar no link de tradução, um serviço gratuito de tradução será ativado para converter a página para o Português. Como em qualquer tradução pela internet, a conversão não é sensivel ao contexto e pode não ocorrer a tradução para o significado orginal. O serviço de Extensão da Carolina do Norte (NC State Extension) não garante a exatidão do texto traduzido. Por favor, observe que algumas funções ou serviços podem não funcionar como esperado após a tradução.
English is the controlling language of this page. To the extent there is any conflict between the English text and the translation, English controls.
Clicking on the translation link activates a free translation service to convert the page to Spanish. As with any Internet translation, the conversion is not context-sensitive and may not translate the text to its original meaning. NC State Extension does not guarantee the accuracy of the translated text. Please note that some applications and/or services may not function as expected when translated.
Collapse ▲
Beginning January 17th, 2023, the NC State Plant Disease and Insect Clinic (PDIC) will no longer be providing identification …

The 2022 NC OVT Soybean Data is now available online at either the OVT website or the Variety Selection Tool. …
The 74th Annual Crop Protection School will be held Thursday, December 1, 2022, online via Zoom. RSVP is required, …

Introduction When designing grazing systems for outdoor pigs, consider the natural behavior of this species. In addition to their trampling …

Interested in working with other small ruminant producers, livestock extension agents and specialists, and NC Department of Agriculture staff …

The 2022 NC OVT wheat, barley, and oats variety data are now available on the NC OVT website and …
The North Carolina Pollinator Conservation Alliance (NCPCA) will be holding its 5th Annual Pollinator Field Day on September 24th …
Research on sesame as an alternative crop has indicated that it may have promise as a rotational crop in …

9/13/2022 – We published a short article on research conducted to understand the relationship between transplant density and timing …
NC State Extension has a world of the latest research and extension information to help avoid and solve problems …

Did you know that North Carolina wheat makes great biscuits? The type of wheat grown in our state, soft …

European pepper moth (Duponchelia fovealis) is a major, yet largely unrecognized, pest of nursery and greenhouse crops. This exotic …

*This project is funded by the NC Small Grain Growers Association in an effort to address the declining wheat …

The 2022 NC OVT wheat, barley, and oats variety data are now available on the NC OVT website and …

From June 19th through June 25th, the American Mosquito Control Association (AMCA) promoted “Mosquito Awareness Week”. The annual event …

I’ve been getting a few emails and calls about large, menacing-looking black spiders that are often confused for exotic, …

We’ve been getting a lot of inquiries about spiders hanging around and coming inside homes lately. Some have …

We are pleased to announce that the recordings of ALL the presentations at our 2022 Swine Innovation Forum are …

Keeping up with rainfall and dry conditions is easy thanks to Corey Davis, Assistant State Climatologist at the State Climate Office of …

Grapevines require 16 essential nutrients for normal growth and development (Table 9.1). Carbon, hydrogen, and …

In this publication you will find ideas to get you started growing your own edibles. …
A Farmers’ Market Tour is a great way to introduce your program participants to an …


Like other perennial plants, mature grapevines have extensive root systems and therefore, unlike shallow-rooted annual …

To grow more consistent crops and improve your cash flow in years with damaging frost …
This publication discusses and quantifies the economic benefits provided to communities when farmland and forestland …

It is the goal of every beekeeper to maintain healthy, productive colonies. This can only …